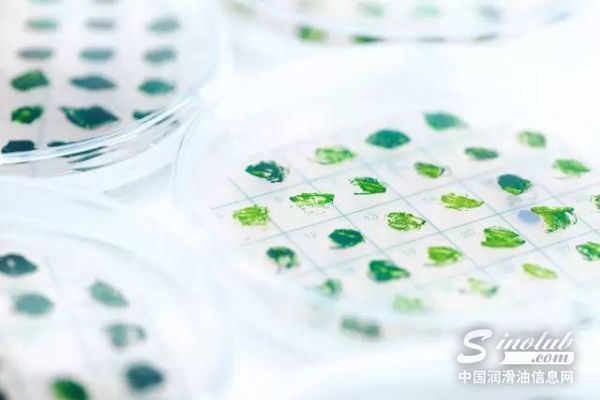
埃克森美孚与SGI延续藻类生物燃料的合作研究

行业观察
左滑下面栏目可查看更多↓汇集中国润滑油信息网基于长期行业观察与行业研究专题输出的判断性文章,围绕润滑油产业发展趋势题,提供阶段性分析与观点解读,反映行业变化中的关键信号与判断结论。
其中,核心判断内容基于「行业研究专题」形成的阶段性研究成果。
注:本栏目为行业判断与观点解读内容,侧重阶段性分析,不构成具体企业或产品评价结论。

聚焦同质配件 汉地润滑油引领汽车后市场供给侧改革
导言日前,国家发改委同有关部门研究起草了《关于汽车业的反垄断指南》(征求意见稿),《指南》中对打破整车厂家对中国零配件市场的垄断,推广汽车同质配件做了规定。中国汽车维修行业协会向汉地润滑科技(中国)有限公司等企业授予“同质配件”试点企业,标志着同质配件试点工作的正式启动。近日,汉地润滑科技···

天津市润滑油脂协会:整合资源,创新科技开拓行业新局面
——专访天津市润滑油脂协会会长李之和先生2016年12月24日,天津市润滑油脂协会成立大会在天津京基皇冠假日酒店隆重召开,全国工商联会、天津市工商联会领导及来自全国各地的石化行业实体企业、行业协会、行业媒体等百余位嘉宾与代表莅临现场,共同见证本次盛典。作为融入汽车和机械基因的润滑油第一门户,中国访···

【金球润滑油头条重磅】免费送车我们是认真的
在茫茫人海中存在着一种神奇并令人向往的品牌叫做金球润滑油在品质上群众说质量是杠杠的技术棒棒哒销量多口碑好不但卖相好 利润还挺高。。。。。。。在营销上月月活动花样多季季服务创新多年年力度猛猛的这两年多的润滑油行业营销创新奖渠道服务创新奖润滑油行业优秀企业家荣誉奖杯我手拿到酸痛了2017年,鸡年吉祥送瑞金球又···

减产遭遇“绊脚石” 国际油价走势趋稳
近几天来,国际石油市场企稳。一方面,欧佩克成员国减产政策开局良好,提振市场信心;但另一方面,美国页岩油生产复苏势头强劲,原油库存量不断攀升,拖累了国际油价上行步伐。今年我国春节长假期间,纽约原油期货价格基本在每桶52美元至53美元附近波动;布伦特油价在每桶55美元至56美元附近波动。在市场人士看来,当前石油···

路博润:中国地区的市场驱动力
引言 过去几年来,随着中国商用车保有量的不断增长,全球的汽车行业都对中国市场投以高度关注。为了满足不断提高的排放标准,对发动机硬件乃至发动机油的性能也提出了更高的要求。让我们通过此文一同了解这背后的原因。过去几年来,全球的汽车行业都对中国市场投以高度关注,原因十分明显。中国的商用车辆保有量在过去几年中···
埃克森美孚与SGI延续藻类生物燃料的合作研究
利用藻类生产经济型、低排放的运输燃料是一个雄心勃勃的目标。但位于美国加州拉荷雅的生物技术企业SGI和埃克森美孚始终坚信这一梦想能够变为现实,这正是为什么两家公司要延续双方的协议,继续研究利用藻类生产清洁、低碳的能源。两家公司的合作研究始于2009年。双方将继续致力于研究如何从藻类中提高脂类的产量。这些脂类的···

激战Bathurst——力魔赞助2017 巴瑟斯特12小时耐力赛
由德国力魔倾情赞助的超级大比赛——2017巴瑟斯特12小时耐力赛于2月3日-5日在澳洲全景山赛道进行。巴瑟斯特12小时耐力赛是一项基于量产车改装的耐力赛事,该赛事源于历史悠久的巴瑟斯特1000赛事。随着巴瑟斯特1000在房车方向上越走越远,巴瑟斯特12小时应运而生,于每年2月在澳大利亚新南威尔士州巴瑟斯特市举办。···

康普顿启程2017
2017年2月3日上午,康普顿创始人朱振华先生带领公司管理层给各个部门拜年,康普顿新的一年启程。一大早,公司管理层对员工进行了新春慰问,给他们送去了新春的祝福和美好的祝愿。青岛康普顿石油化工有限公司董事长朱磊先生亲切地与岗位上的干部职工握手问候,互祝新春快乐。所到之处,无不充满欢声笑语,广大员工深深感受到···

欧美润滑油:创新需要稳扎稳打
——专访欧美润滑油董事长吕金水先生随着汽车保有量的节节攀升,车用润滑油市场的持续火爆,行业蓝海也逐渐演变为竞争激烈的红海。在众多新兴民营润滑油品牌如春笋般涌现的同时,也有越来越多经受不住转型升级阵痛的民营品牌黯然退场。面对行业“新常态”,作为国家高新技术企业,欧美润滑油始终稳扎稳···

金属切削液的作用机理
金属切削液的选择和使用应当根据工件材料、刀具材料、加工方法和加工要求,选用不同的金属切削液。如选择不当,就得不到应有效果。高速钢刀具粗加工时,应选用以冷却作用为主的金属切削液,主要目的是降低切削温度;硬质合金刀具粗加工时可 以不用金属切削液,必要时也可以来用低浓度的乳化液或水溶液,但必须连续地、充分地···














